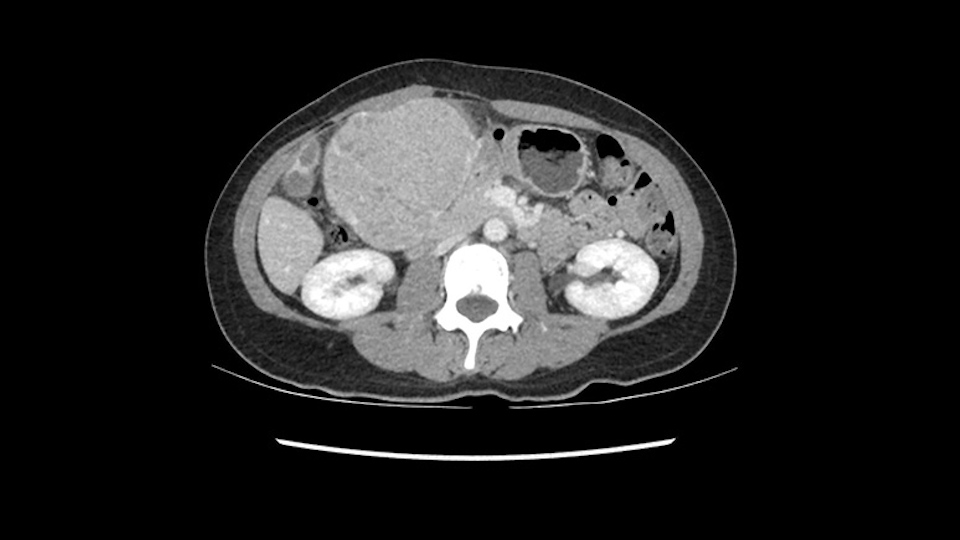
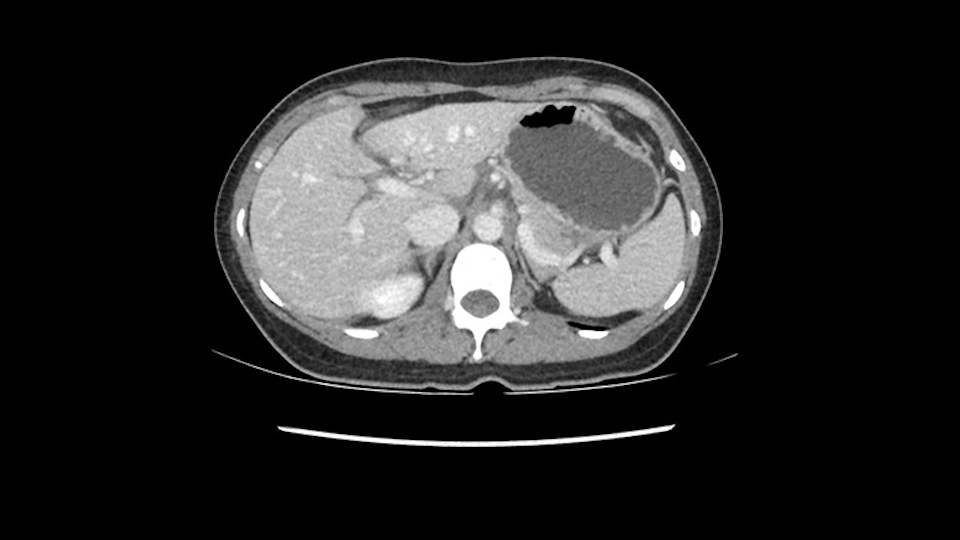

International Hepato-Pancreato-Biliary Association
Left lateral sectionectomy [case 12]
Surgeon's Impressions
Watch the following videos of several surgeons' preoperative plans for the case. Compare their findings with your own analysis.
Dr. Gallinger's critical imaging findings:
Uncertain location of the tumor
Possible procedures: Sg2-3 wedge resection, Left lateral sectionectomy, Left hepatectomy
Hi my name is Steven Gallinger. I’m professor of surgery at the University of Toronto and a hepatobiliary and pancreatic surgical oncologist at the University Health Network. This patient is a 41-year old who we saw recently with chronic Hepatitis B who is untreated and noticed a protrusion in her upper abdomen and after a series of investigations was found to have this hypervascular liver lesion. Her alpha fetoprotein was about 26000 so the diagnosis really wasn’t in question. Although we did review the diagnostic imaging at our tumor boards last week and the consensus was that this is a hepatoma. The patient had good liver function, actually perfect liver function biochemically. Considering the location of this lesion and her age and alternative treatments, we felt that resection would be the best approach for this tumor.
So if we look at the CT scan, on the axial, it’s a larger lesion. It’s about 6 or 7 or 8 centimeters. So it does look a bit threatening in terms of its resectability but if you really drill down deeply into the anatomy, and I think the coronal [imaging] is even better, you can see that the entire mass is on the patient’s left side of the falciform ligament. So it’s really only a left-sided tumor and not even really a left-sided tumor because Segment 4 is uninvolved anatomically.
None of the parenchyma is affected and this tumor is very exophytic; like many Hepatitis B hepatomas; and otherwise is resectable with either a wedge resection part of Segment 2-3 or a formal left lateral segmentectomy.

Some of my colleagues thought it may be involving Segment 4 and we’d need a formal left hepatic lobectomy, dividing anatomically: the left portal vein, left hepatic artery, left bile duct. But I didn’t think so, but you can see there is a challenge in terms of being certain where this tumor is located. So we’re prepared to do any of those 3 but my person view is that its going to be an exophytic tumor off of the left lateral segment and probably a wedge.

Anatomically, to plan for a left lateral segmentectomy, it’s relatively easy as far as liver surgery goes. I know that I'm going to be looking for the left hepatic vein which will be divided at some point either towards the end at the back near the vena cava or through the middle of the left lateral segment.
Inflow is not usually an issue except if there are as a replaced or aberrant left hepatic artery. In which case you’d be careful when you mobilize the left lateral segment.
I generally take the ligamentum venosum to get access to the left hepatic vein. In this case, not necessarily but we certainly need to think about it.
Otherwise, the dissection at the porta is on the left side of the falciform [ligament] so we don’t worry too much about any of the other major structures. This is really an operation more of avoidance by staying far into the periphery as opposed to worrying about the porta. So we prepared her for surgery and she consented and was anxious to proceed.
Dr. Greig's critical imaging findings:
Dissection of left portal vein
Ultrasound to determine tumor proximity to left portal vein
Sg2-3 left hepatic artery
Preserve caudate lobe
Caudate branch of left portal vein
Sg3 (falciform) vein from left hepatic vein
Preserve middle hepatic vein
My name is Paul Greig. I’m a professor of surgery at the University of Toronto. My area of interest is hepatobiliary surgery and transplantation. The information I have is: its a 41-year old woman known to be a Hepatitis B carrier who recognized a mass in her abdomen. Investigation has shown this large vascularized tumor in the left lobe of her liver. I’m told that her liver function is normal and she’s otherwise well.
As I review the CT scan, we have both arterial and venous phases, the tumor is obvious. But I’ll start by saying that the liver itself does not appear to be cirrhotic to my eye. It’s got a normal contour and allied to that, that I do not see evidence of portal hypertension. The spleen is normal, there’s no collateral vessels. The tumor itself, I measured maximally at about 11 centimetres in diameter and I’m told the alpha fetoprotein is very high (over 10000), which is entirely consistent with this being a solitary hepatocellular carcinoma that is very exophytic. It seems to emanate off the inferior margin of Segment 3 (because that’s the falciform). I’ll start by saying that this is not transplantable. The tumor exceeds our guidelines for transplantation, but it's likely resectable based on normal liver and no portal hypertension.
So the issue with regards to resection. A left sided tumor. I believe I can see the falciform ligament right here so we’re looking at a resection of Segments 2, 3 of the left lobe of the liver. The left portal vein is right there. I think we’ll be wiser to take the left portal vein and therefore get well into Segment 4 and do a left hemihepatectomy. Certainly, one does not need to take the middle hepatic vein; it’s miles from the tumor.

We note that the tumor is pushing on the gallbladder but I think that’s probably external for the most part. I think that’s extrahepatic. I believe that Segment 4b is probably free of tumor. I’d have to say that it's tempting, particularly looking at the coronals, to consider a very limited resection. Where you’d just chip it off the bottom of Segment 3 and do a limited Segment 3 resection. I’d be concerned about the oncologic margins. I believe that the best oncologic operation will be to take the left portal vein to get this. Certainly, she’s got plenty of liver and she’d be able to sacrifice Segments 2-3 of the left lobe of the liver. It’s not necessary to take too much of thus of Segment 4a. But once one takes the portal vein, that will be compromised. So I would do a left hemihepatectomy on this woman.

So I have to say that I would do this open, not laparoscopically because of the size of the tumor itself. Upper abdominal incision. Almost certainly, we’d be able to flip this very exophytic lesion up. Intraoperative ultrasound will show the relationship of the tumor and the left portal vein but the dissection at the base of the liver, as I look at things here, I can see the left hepatic artery which sneaks up to the left of the portal vein, should be out of harm’s way so I can take the Segment 2-3 left hepatic artery. The left portal vein is somewhat compressed. But by the time you pull the liver up a bit, you’ll be able to pull that left portal vein out to length and get a good margin on it.

My plan would be to leave the caudate lobe intact. You usually have to divide the caudate branches. I can see one of the caudate branches here coming off the left portal vein. You usually have to take that to get adequate length although you might be able to divide the portal vein past that left caudate branch.
The transection line will be a little more obvious. There’s a little patch of focal fat here in Segment 4b but we’ll describe the transection line probably through the mid portion of Segments 4a and b up to the top. Up at the top, the left hepatic vein can be taken. There’s a Segment 3 vein or the so-called falciform vein it’ll be rudimentary so I think we’ll be able to get around the left hepatic vein and leave the middle [hepatic] vein intact because it’s free of tumor.
Dr. Karademir’s imaging findings:
Tumor proximity to Sg4b
Intraoperative ultrasound
Possibly extending to right side of falciform ligament
Encircle common trunk of middle, left hepatic vein
Check for invasion to hepatic pedicles, arteries
Intraoperative decision to preserve Sg4
Hi my name is Sedat Karademir. I’m from Ankara Guven Hospital and I’m an HPB and transplant surgeon. We are discussing about the case I reviewed the CT of 41 year old lady with a suspected hepatoma in the left lateral segment. Presumably its Segment 3. It looks like a big tumor sitting exophytically mostly out of the liver and pressing on the surrounding organs, but it doesn’t look like any invasion there. In this situation, according to the venous and arterial anatomy, it looks like this will be a Segment 2 and 3 resection.
The tumor is so close to the falciform ligament, I had a question mark about the Segment 4b relation between segment 4b and segment 3. In a normal resection of segment 2 and 3, we would be keeping on the left side of the falciform ligament and start getting segment 3 and 2 portal pedicles but in here its getting so close. So oncologically, 4b should be checked during the OR.
Intraoperative ultrasound will be a good way of checking. Also we can feel it in between the tumor and the resection margin will be safe enough. If it is not, I think we have to go to the right side of the falciform ligament and try to get a better resection margin. And we know this is - actually we don’t know, but this looks like fibrolamellar HCC and should have a good capsule; but it needs to have a good oncological margin also. 
Her vein, it looks like a combined middle and left hepatic vein, it may be encircled during the case as a whole common trunk but most probably it will not be a big deal because if it is okay to go with the left lateral resection, the vein or the left hepatic vein can be catched during the intraparenchymal dissection and can be controlled in that side.
So what I would do, I would find out most probably this mobile tumor, it would not be a problem to explore the hepatic pedicle and check, find out no other invasion around the pedicle; and we have to check the left artery as well. The right side artery is fine. If there is any replaced arteries, we have to know during the case, may be or may not be preserved. It would not be a big problem actually because the right side will feed it.
If it is so exophytic, looks like a small attachment with the Segment 3 medial side (which is not good) – but if it is enough good margin and we can protect and avoid getting to Segment 4, Segment 2 and 3 may be doable. But during the case, if I feel that I will not have enough resection margin, which in fibrolamellar HCC needs a good margin, if I cannot achieve that, I would go for Segment 4 resection and include it into the operation too. But first Segment 2 and 3. Check the tumor if it is doable, but if it is not, then I will add Segment 4 into the specimen. Thank you.
Dr. P Jagannath’s critical imaging findings:
PV branching
Identify, preserve RHA
Tumor proximity to duodenum
Tumor proximity to vena cava
Exophytic tumor
I’m Dr. Jagannath, surgical oncologist with interest in hepatobiliary surgery. This is an interesting case. A 41 year old woman who has Hepatitis B. There are very interesting findings on the CT which you need to be extremely careful when you evaluate.
When you see the axial sections of the scan, you find it's a largely exophytic mass and its well-encapsulated. So this is typically true of a well-differentiated hepatocellular carcinoma. If you look at this, this is the gallbladder which is being displaced to the right and the mass is in the Sg4 of the liver, exophytic, projecting down. As it is coming down, it is also displacing the duodenum and the head of the pancreas which is being pushed towards the left and it's going right up to the cava, the start of the anterior surface of the cava. Obviously getting a lot of collaterals and vascularity from all the vessels around but one has to be very careful in evaluation of the main portal pedicle in this particular case and of course arterial inflow to the Sg4 and of course the left lobe of the liver.
What kind of procedure can we plan for this patient? It obviously has to be a left hemihepatectomy because most of the lesion is actually in Sg4. Can we do something which is less than a hemihepatectomy and just do only a segmental resection? The answer to that is that this vascular supply, if you are trying to ligate only the portal venous pedicle to the Segment 4, it is very close to the tumor and you will end up not having not a great margin as far as tumor resection is concerned so I would recommend a left hemihepatectomy and not just a partial or segmental resection. You can also see that it is crossing the falciform line and going on to Segment 2 and 3 so trying to do anything less than a left hemihepatectomy may not give the right kind of margins which we need for this tumor. Fortunately for us, the contours of the liver, which are very important to see in a Hepatitis B patient, there are no cirrhosis which I can see. The normal liver functions indicate that it's a well compensated Hepatitis B.
Now let’s look at some specific anatomical points for planning this surgery. First thing you see when you see a left hemihepatectomy is that where is the left portal vein and the right portal vein branching? And what is the stump of the left portal vein available for you for ligation? In this particular case, you’ll find that there’s overhanging of the tumor but left portal vein pedicle is sufficiently available for us for ligation. 
The second is the left hepatic artery. The tumor is displacing the arterial system. So one of the important points which we need to see intraoperatively is to identify and preserve the right artery very carefully and identify the left hepatic artery for ligation. 
Now coming to the duodenum, we can see that the stomach is coming down, and as it comes down to the head of the pancreas, it’s compressed by the mass which is distorting the duodenum completely. Is there invasion of the duodenum or not? When you see a little above, there is a very well nicely capsulated tumor so my impression is that it is only displacing the duodenum, may not be invading the duodenum. But however intraoperatively one has to be careful in dissecting the duodenum from the tumor. 
The cava however is again displaced by this well encapsulated mass, so I would expect that I should be able to lift out of the cava with some moment of careful dissection and the cava is not infiltrated by this tumor. Most of the tumor is below the portal plane and the hepatic-venous vein is completely free. You have the left and the middle hepatic vein joining together and opening up. The right hepatic vein is as usual. All the superior segments of the liver are intact so we do not expect any major problem in this particular case as far as the venous outflow is concerned. So this is about the preoperative planning as far as this case is concerned.
Now lets very carefully look at how and where to structure the mobilization of the liver. I don’t see a very thick abdominal wall so this patient is fit. My preference is a Makuchi kind of an approach where you have a vertical limb and then if necessary it goes down the costal margin on to the right side.
The next step would be to carefully palpate and make sure that this adherence to any vascular structures is not there. I would start off by slowly mobilizing it from the duodenum inferiorly and lift the tumor up and expose the portal pedicle on the top. The portal pedicle and the hepatic arterial system has to be carefully traced. I want you to really slow down at this point of time and anatomically identify each of the vascular structures we are mentioning right now. Where is the proper hepatic artery, and where is the branching into the left and right hepatic arteries. Many times a left hepatic artery is given off early which is good for us and also when you go up on to the hilum, you find that the gallbladder is very close and adherent to the tumor so one has to work on the plane of the common bile duct, identify the cystic duct, ligate the cystic duct, and perhaps even leave the gallbladder on to the tumor and not try and dissect it from the tumor because the plane of transection will be at the Cantlie’s line which is the gallbladder fossa. Once you do this, then you go up and you need to take the portal bifurcation from below and of course the arterial supply to the segment which we are resecting.
Once you identify the inflow of the left portal vein and the hepatic artery, its always a good idea to ensure that the bile duct is also carefully seen and preserved. The problem with the bile duct is it is thin and it might have a biliary variation which you are not appreciating on a CT scan. If there is a biliary variation, one has to be very careful not to injure the right ductal system and when you are resecting the left lobe of the liver. This is particularly true because you are having an overhanging tumor and that can distort the anatomy so one has to be careful and slow down when you are trying to ligate or identify the biliary system. It’s a good idea just to loop up the vessels, identify them and then ligate them only when you are certain that you are preserving the vasculature to the right side. I’ll prefer to ligate the inflow at this point of time. The left hepatic artery and the left portal vein to be ligated.
The next step would obviously be the left hepatic vein mobilization. Once you lift the left lateral segment up, and you mobilize from the caudate lobe, you’ll find that you need to identify [Arantius’ canal] and ligate [Arantius’ canal], then only the left hepatic vein comes into view at the apex of the caudate lobe. In this particular case, because the hepatic venous plane is intact and its pretty free, it’s quite easy to ligate the left hepatic vein and staple it off. That would complete the devascularization of the tumor. 
In this particular case, Cantlie’s line would be the right place to split so any kind of a major hepatectomy through the principal plane of the liver is far easier than doing a segmental resection. I split by using a FOCUS. I developed a technique called a FOCUS-clysis, which has a harmonic energy and I also use it like a Kelly-clysis so you pinch the liver. When you come to the blood vessels, anything which is 2 to 3 millimetres can easily be coagulated by using harmonic energy; you can split the liver in a good time.
I do not prefer to have a Pringle maneuver because a hemi-occlusion is sufficient for this patient, you are not hurrying up, the vascularity to the right lobe is preserved throughout the surgery and there is certainly no need for us to panic and split in a hurry.
I must also add that intraoperative ultrasound is an extremely valuable tool to ensure that you have identified the middle hepatic vein and also you identify any kind of disease on the other side, the vascular anatomy and reconfirm on intraoperative ultrasound. 
So most important thing however in this particular case is because it’s exophytic and because it has a capsule, at no point of time should it be ruptured. So one has to be very careful in handling such large exophytic tumors which is important for the overall results of the surgery.
Dr. Sapisochin’s imaging findings:
RHA, Sg4 artery not involved in tumor
LHA feeding branches to tumor
Surrounding structures compressed by tumor
Right lobe, Sg4 not involved
Two possible procedures: Local resection Sg3, Left hepatectomy
My name is Gonzalo Sapisochin. I’m an assistant professor of surgery at the University of Toronto and a hepatobiliary and pancreatic surgical oncologist here at the University Health Network. So this patient has a big mass, likely growing from the left lobe of the liver, around 9-10 cm.
So in planning for this operation, as I look at the scans, I first visualize the arterial phase and I can see that there’s are a lot of big feeding arteries to this large tumor. Likely all the right side vessels feeding the right side of the liver: right hepatic artery and likely the Segment 4 artery are spared from the tumor. It’s likely the left hepatic artery is ramificating and giving feeding arteries to this tumor. It certainly looks like a large mass that its compressing other structures like the cava, the pancreas, the stomach; but I think there’s a plane and we can see that better in the venous phase. There’s a plane of separation between the gallbladder, the pancreas, the cava, that this tumor is abrupting but likely not invading. Usually, these masses actually don’t invade at that level and basically are pushing the tissues and once you open, you’re able to separate the tumor. Sometimes there’s some adhesions but you can actually separate and there’s usually no invasion.

The other thing I would do in this case is to certainly to assess the coronal phase as we can see in the coronal phase, this tumor looks like it's growing from Segment 3, and again I don’t think there’s involvement of the right side of the liver or even on Segment 4.
So in terms of planning on the surgery, I think there’s two clear options for this patient and that we’ll need to assess once we’re in the operating room. One option would be to do a Segment 3 resection. This tumor seems like it's hanging from Segment 3 so I think if we can get a good margin, that would be an option. Of course the other option is to do a left hepatectomy, preserving the middle hepatic vein, which is clearly not involved with the tumor.

So, if we’re going to do a local resection or basically resect Segment 3, I would likely evaluate how the tumor is and then transect the parenchyma and in some of these cases I will perform a Pringle procedure to avoid bleeding. That would be the simplest operation and the best operation for her in terms of recovery. I would try and find the pedicle going to Segment 3 and try to do an anatomical Segment 3 resection, as there is some data suggesting that anatomical resection has better outcomes for Hepatocellular Carcinoma if this is what it is.
The other option of course is to do an anatomical left hepatectomy. In that case, I will start mobilizing of course the left lobe and try to find the ligamentum venosum, take it down and go around the left hepatic vein. I think, importantly in these cases and in this case, as you can see in the venous phase, that’s clearly a moment to stop. Because the left hepatic vein is pretty close to the middle hepatic vein as sometimes it is so you may need to dissect a little bit the parenchyma on top of the left hepatic vein to be able to go around the left hepatic vein safely.
Then I will turn my attention to the porta and I will dissect (and I usually go very high on the parenchyma) the left hepatic artery and likely the Segment 4 artery. Then I will take the left portal vein likely with a stapler. Very importantly, once you’re on the plane of transection, once you start transecting the liver, just on the right of the left hepatic vein, once you get to the plate and you’re far from the tumor it’s very important to change your plane of transection and quickly go to the left to avoid injuring the bile duct bifurcation or even the right hepatic ducts. I always transect straight down and once I’m getting close to the plate, I always make sure the plane gets transversely and really go into the left. That’s another key factor with a left hepatectomy. Otherwise, I think these are the key features from this case and there are two potential operations that could be done.
Las cosas importantes del paciente por Dr. Sapisochin:
Muchas ramas de la arteria hepática izquierda al tumor
Estructuras vasculares derechas estan libres de tumor
Compresión de estructuras
Dos reseccións posibles:
- Resección del Sg3
- Hepatectomia izquierda
Hola mi nombre es Gonzalo Sapisochin, soy un assistant proffesor aquí en la Universidad de Toronto y un cirujano Hepato pancreático, hacienda cirugía oncológica hepato pancreática aquí en University Health Network. El paciente que estamos discutiendo hoy es una mujer de 41 años con hepatitis B que ha sido diagnosticado con una gran masa, aproximadamente 9cm to 10 cm, parece que esta masa cuelga del segmento 3 del hígado izquierdo tiene una alfafetoproteina de 26000 y probablemente se trate de hepatocarcinoma fibrolamellar, o un hepato carcinoma. El plan quirúrgico para ella es realizar una hepatectomia izquierda y vamos a discutir cuando uno planeo este tipo de cirugías en estos pacientes hay determinadas características que tennos que pensar, primero en el paciente y si podemos hacer esta cirugía; y en segundo lugar hay algunas características y cosas importantes de la cirugía que vamos a discutir en un momento.
Lo primero es pensar en el paciente y por supuesto tenemos que confirmar que no hay enfermedad extra hepática. La paciente tiene una alfafetoproteína de 26000 que esto claramente es un factor de riesgo para una enfermedad extra hepática
En cuanto a la técnica quirúrgica lo primero que hago es mirar al escáner a la fase arterial que tenemos aquí y claramente ese ve como los hepatocarcinomas son tumores muy vascularizados se pude como las ramas de la arteria hepática izquierda hay muchas ramas nutriendo a este tumor, parece que son bastantes grandes. Parece claro que todas las ramas yendo al hígado derecho están libres de tumor y yo no creo que haya ninguna invasión vascular en este caso. Y como se puede ver hay una gran masa que insisto parce que cuelga del segmento 3.
Lo siguiente que voy a hacer es mirar a la fase venosa. Y otra vez parece que todas las estructuras yendo al hígado derecho, es decir, tanto la vena porta derecha, la vena porta principal parece que están libres de tumor. Lo que si parce es que este tumor está comprimiendo diferentes estructuras, parece que comprime el páncreas, puede que este comprimiendo la cava, la vesícula biliar, pero en la mayoría de estos casos estos tumores no invaden estas estructuras, muy probablemente sea simplemente compresión, y una vez hallamos hecho la laparotomía es probable que todas estas estructuras queden separadas del tumor y puede que haya algunas adherencias que se puedan resecar sin problemas.

La decisión aquí, y otra vez mirando, me parce importante mirar a los cortes coronarios porque parece que este tumor cuelga del segmento tres y aquí la cuestión va a ser si vamos a realizar una resección más limitada y hacer una recesión del segmento tres, o si vamos a tener que realizar una hepatectomia izquierda. En cuanto a puntos importantes en ambas opciones, en todos los casos vamos a intentar realizar un recesión anatómica ya que hay datos en la literatura que parecen indicar que una resección anatómica tiene mejores resultados oncológicos comparado con una recesión no anatómica; entonces realizaremos una resección del segmento tres y en este caso trataremos de buscar el pedículo que va al segmento tres, en este caso probablemente sea una resección del segmento tres, realizare una maniobra de Pringle y clampare el hilio para evitar el sangrado.
En cuanto a la hepatectomia izquierda aquí creo que la clave va a ser disecar bien el ligamento venoso y poder ir pasar una cinta alrededor de la vena hepática izquierda, en este caso parece que al vena hepática izquierda está muy junta, como en muchos casos a la vena hepática media, a ser importante disecar bien la vena supra hepática izquierda para poder pasar alrededor de ella sin dañar la cava o la vena hepática media. Una vez que hayamos hecho esto pasaremos a mirar la porta, y yo siempre tiendo a disecar las estructuras lo mas próximas al hígado posible, disecaremos la arteria hepática media rama del segmento 2-3 y la rama del segmento 4 si estamos haciendo una hepatectomia izquierda, y insisto parce que este tumor además tiene otras muchas ramas que van directas al tumor que habrá que ligar, eso nos dará acceso a la vena porta izquierda que probablemente resecare con una grapadora lineal, y finalmente transectarmos, haremos la transeccion hepática.

Aqui la clave al hacer una hepatectomia izquierda es una vez que llegamos a la bifurcación de la placa hilial, es realmente pensar que hay que cambiar el plano y realizar un plano transversal para evitar dañar la bifurcación de la placa hilial o incluso el pediculo derecho, y esto es una cosa que siempre insistimos en quirófanos, que es cambiar el plano y horizontalizar el plano hacia la izquierda. Y yo creo que esto básicamente las cosas importantes en este caso y va a ser discernir que tipo de hepatectomia vamos a realizar.
Acknowledgements
Thank you to the HPB Surgeons who contribute their time and expertise. This content is made possible through educational grants from:
Case 28

Views and opinions expressed in all videos and module content are those of the individual surgeon and solely intended for surgical education purposes. We do not endorse any product, treatment or therapy.
Corporate Partners
If you are interested in becoming a Corporate Partner of the IHBPA please contact industry@ihpba.org
Find out more
Go to myHPB
